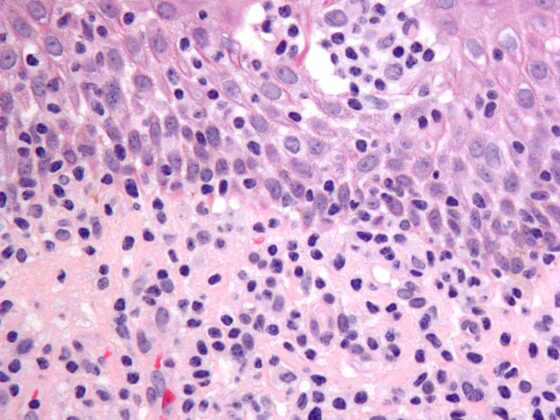

Wichtige Therapieziele bei chronischer Herzinsuffizienz sind die Verbesserung der Lebensqualität, sowie die Verringerung des Hospitalisations- und Mortalitätsrisikos. Gemäss aktueller Evidenzlage erzielt eine leitliniengerechte Therapie mit den vier Wirkstoffgruppen ACE-Hemmer/ARNI, Betablocker, Mineralokortikoid-Rezeptorantagonisten und SGLT-2-Hemmer die besten Effekte. Dies konnte in verschiedenen Studien belegt werden.
Autoren
- Mirjam Peter, M.Sc.
Publikation
- HAUSARZT PRAXIS
Related Topics
Dir könnte auch gefallen
- Vom Symptom zur Diagnose
Pneumologie – Covid-19: ein Rückblick
- Altersbedingte neurokognitive Störungen
Neuroprotektive Wirkungen des Ginkgo-biloba-Extrakts
Wie Herkunft und Wohnort den CF-assoziierten Diabetes fördern
- Pankreaskarzinom
Innovative Früherkennung mit Fokus auf Liquid Biopsy und KI
- Vom Symptom zur Diagnose
Abdominalschmerz – Prostataabszess
- Asthma in der Schwangerschaft
Bis zu 40% erleiden Symptomverschlechterung während der Gravidität
- Vom Symptom zur Diagnose
Komplizierte Nierenzysten
- Schweres Asthma und CRSwNP